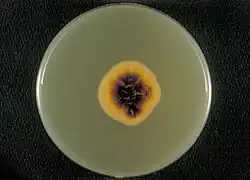
Onderkant van voedingsbodem met Sabouraud’s dextrose agar

Trichophyton rubrum
| Trichophyton rubrum | |||||||||||||
|---|---|---|---|---|---|---|---|---|---|---|---|---|---|

| |||||||||||||
| Macroconidium en enkele microconidia van Trichophyton rubrum var. rodhaini | |||||||||||||
| Taxonomische indeling | |||||||||||||
| |||||||||||||
| Soort | |||||||||||||
| Trichophyton rubrum (Castel.) Sabour. (1911) | |||||||||||||
| Afbeeldingen op | |||||||||||||
| Trichophyton rubrum op | |||||||||||||
| |||||||||||||
Trichophyton rubrum is een schimmel die bekendstaat als de gebruikelijke veroorzaker van zwemmerseczeem en onychomycose en behoort tot de dermatofyten. De schimmel werd voor het eerst beschreven door Malmsten in 1845.[1] In Europa komt de schimmel steeds meer voor. In het laboratorium op een voedingsbodem varieert de groeisnelheid van Trichophyton-kolonies van langzaam tot tamelijk snel. De textuur is wasachtig tot katoenachtig. Kleuren variëren van wit en beigegeel tot bruin. De onderkant van de voedingsbodem is wijnrood gekleurd. Op een voedingsbodem worden er talrijke, peervormige microconidiën gevormd, die aarvormig bij elkaar zitten. Macroconidiën worden zelden gevormd en zijn sigaarvormig met 2 - 7 tussenwanden.
Identificatie van de schimmel is lastig omdat veel andere schimmels uit het geslacht Trichophyton met de test reagens een vergelijkbare reactie geven.
De schimmelinfectie krijgt zijn kans op vochtige plaatsen van de huid en begint meestal op het hoofd (tinea capitis) of de voeten (zwemmerseczeem = tinea pedis), maar kan op het gehele lichaam voorkomen.
De schimmel vormt ringvormige plekken en leeft van de keratine, dat voorkomt in de buitenste dode cellen van de huid en nagels. De infectie veroorzaakt jeuk en een rode, schilferige huid. Als de schimmel zich uitbreidt, worden de ringen steeds groter, terwijl vanuit het aangetaste centrum weer genezing plaatsvindt.
- Trichophyton rubrum
-
 Micro- en macroconidién
Micro- en macroconidién -
 Trichophyton rubrum op voedingsbodem
Trichophyton rubrum op voedingsbodem -
Onderkant van voedingsbodem met Sabouraud’s dextrose agar
Onderkant van voedingsbodem met Sabouraud’s dextrose agar -
 Ringworm
Ringworm
Zie ook
- ↑ William Williams, The Principles and Practice of Veterinary Surgery, p.734, W.R. Jenkins, 1894, from the collection of the University of California.